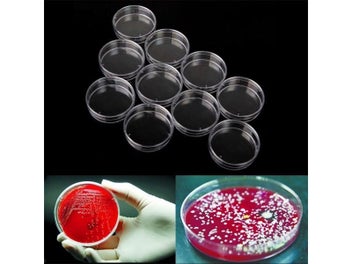

Petri Dishes
Whether you are looking to buy a business, pick out some office furniture, or want farming and forestry equipment, you can find it all here. Look through the listings below or check out our categories to see what's for sale and find the items you're after.
- Industrial (225)
- Office equipment & supplies (4)